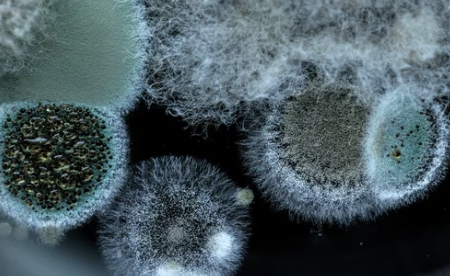

🐶 우리 강아지, 혹시 피부병?! 😨 강아지 피부병 종류 완벽 정복! 🐶
안녕하세요, 반려견과 함께 행복한 삶을 꿈꾸는 여러분! 오늘은 우리 사랑스러운 강아지들을 괴롭히는 피부병에 대해 자세히 알아보려고 합니다. 강아지 피부는 사람보다 훨씬 예민하기 때문에 각별한 관리와 주의가 필요한데요, 다양한 피부병 종류와 증상, 예방법까지 꼼꼼하게 알려드릴 테니 끝까지 함께해 주세요! 😊
1. 🐕 흔하지만 무시하면 안 돼요! 세균성 피부염 🐕



세균성 피부염은 강아지에게 가장 흔하게 발생하는 피부 질환 중 하나입니다. 피부에 상처가 생기거나 면역력이 약해졌을 때 세균이 침투하여 염증을 일으키는 질환이죠.
- 주요 증상: 붉은 반점, 가려움증, 농포, 탈모 등
- 원인: 세균 감염, 면역력 저하, 알레르기, 호르몬 불균형 등
- 치료: 항생제, 소독약, 약용 샴푸 등을 사용하여 치료합니다.
저희 집 강아지도 한번 세균성 피부염에 걸린 적이 있었는데, 털이 빠지고 붉은 반점이 생겨서 너무 속상했어요. 😭 하지만 초기에 발견해서 병원 치료를 받고 꾸준히 관리해주니 금방 회복할 수 있었답니다.
2. 곰팡이가 원인이래요! 😱 곰팡이성 피부염 😱

곰팡이성 피부염은 곰팡이균에 감염되어 발생하는 피부 질환입니다. 사람에게도 전염될 수 있으니 주의해야 합니다.
- 주요 증상: 원형 또는 타원형의 탈모, 비듬, 가려움증, 악취 등
- 원인: 곰팡이균 감염
- 치료: 항진균제, 약용 샴푸 등을 사용하여 치료합니다.
3. 잠 못 드는 밤! 괴로운 가려움, 알레르기성 피부염 🤧



알레르기성 피부염은 특정 물질에 대한 알레르기 반응으로 발생하는 피부 질환입니다.
- 주요 증상: 심한 가려움증, 발진, 붉은 반점, 탈모 등
- 원인: 음식 알레르기, 꽃가루, 집먼지 진드기, 벼룩 등
- 치료: 알레르기 원인 물질을 파악하고 회피하는 것이 중요합니다. 항히스타민제, 스테로이드 등을 사용하여 증상을 완화할 수 있습니다.
저희 강아지는 닭고기 알레르기가 있어서 사료를 바꾸고 난 후 알레르기성 피부염 증상이 많이 좋아졌어요. 😊
4. 탈모가 심해요! 😥 호르몬성 피부염 😥



호르몬성 피부염은 호르몬 불균형으로 인해 발생하는 피부 질환입니다.
- 주요 증상: 대칭적인 탈모, 피부 얇아짐, 색소 침착 등
- 원인: 갑상선 기능 저하증, 쿠싱 증후군 등 호르몬 불균형
- 치료: 호르몬 검사를 통해 원인 질환을 파악하고 치료해야 합니다.
5. 외부 기생충이 문제! 벼룩 알레르기 피부염 벼룩



벼룩 알레르기 피부염은 벼룩에 물렸을 때 발생하는 알레르기 반응입니다.
- 주요 증상: 심한 가려움증, 발진, 붉은 반점, 탈모 등
- 원인: 벼룩
- 치료: 벼룩 제거 약을 사용하여 벼룩을 제거하고, 항히스타민제나 스테로이드 등을 사용하여 증상을 완화할 수 있습니다.
6. 🐶 소중한 우리 강아지, 피부병 예방하려면? 🐶



- 정기적인 목욕: 털과 피부를 깨끗하게 유지하여 세균이나 곰팡이균 번식을 막아줍니다.
- 균형 잡힌 식단: 건강한 피부와 면역력 유지를 위해 양질의 사료를 급여하고, 알레르기 유발 음식은 피해야 합니다.
- 벼룩 예방: 벼룩 예방 약을 정기적으로 사용하여 벼룩 감염을 예방합니다.
- 스트레스 관리: 스트레스는 면역력을 약화시키고 피부 질환을 악화시킬 수 있으므로 적절한 스트레스 관리가 필요합니다.
- 정기적인 건강검진: 정기적인 건강검진을 통해 피부 질환을 조기에 발견하고 치료하는 것이 중요합니다.
7. 마무리하며: 강아지 피부 건강, 함께 지켜요! ❤️
강아지 피부병은 종류도 다양하고 원인도 복잡하지만, 꾸준한 관심과 관리를 통해 충분히 예방하고 치료할 수 있습니다. 오늘 알려드린 정보들이 반려견의 피부 건강을 지키는 데 도움이 되길 바랍니다.
"반려견의 피부는 우리의 사랑과 관심을 필요로 합니다. 작은 변화도 놓치지 말고, 궁금한 점은 언제든 수의사와 상담하세요! 건강하고 행복한 반려 생활을 응원합니다!" 😊
'반려견에 대한 모든 것' 카테고리의 다른 글
| 강아지 복숭아먹어도되나요? (6) | 2024.09.19 |
|---|---|
| 강아지가 먹어도 되는 과일 총정리 ✅ (6) | 2024.09.12 |
| 메리츠화재 펫보험 보장내용 및 장점 알아보기 (4) | 2024.09.10 |
| 강아지 토마토 먹어도 되나요? (0) | 2024.08.25 |
| 웰시코기 분양, 성격, 종류, 털빠짐, 수명 등 총정리 (0) | 2024.08.10 |